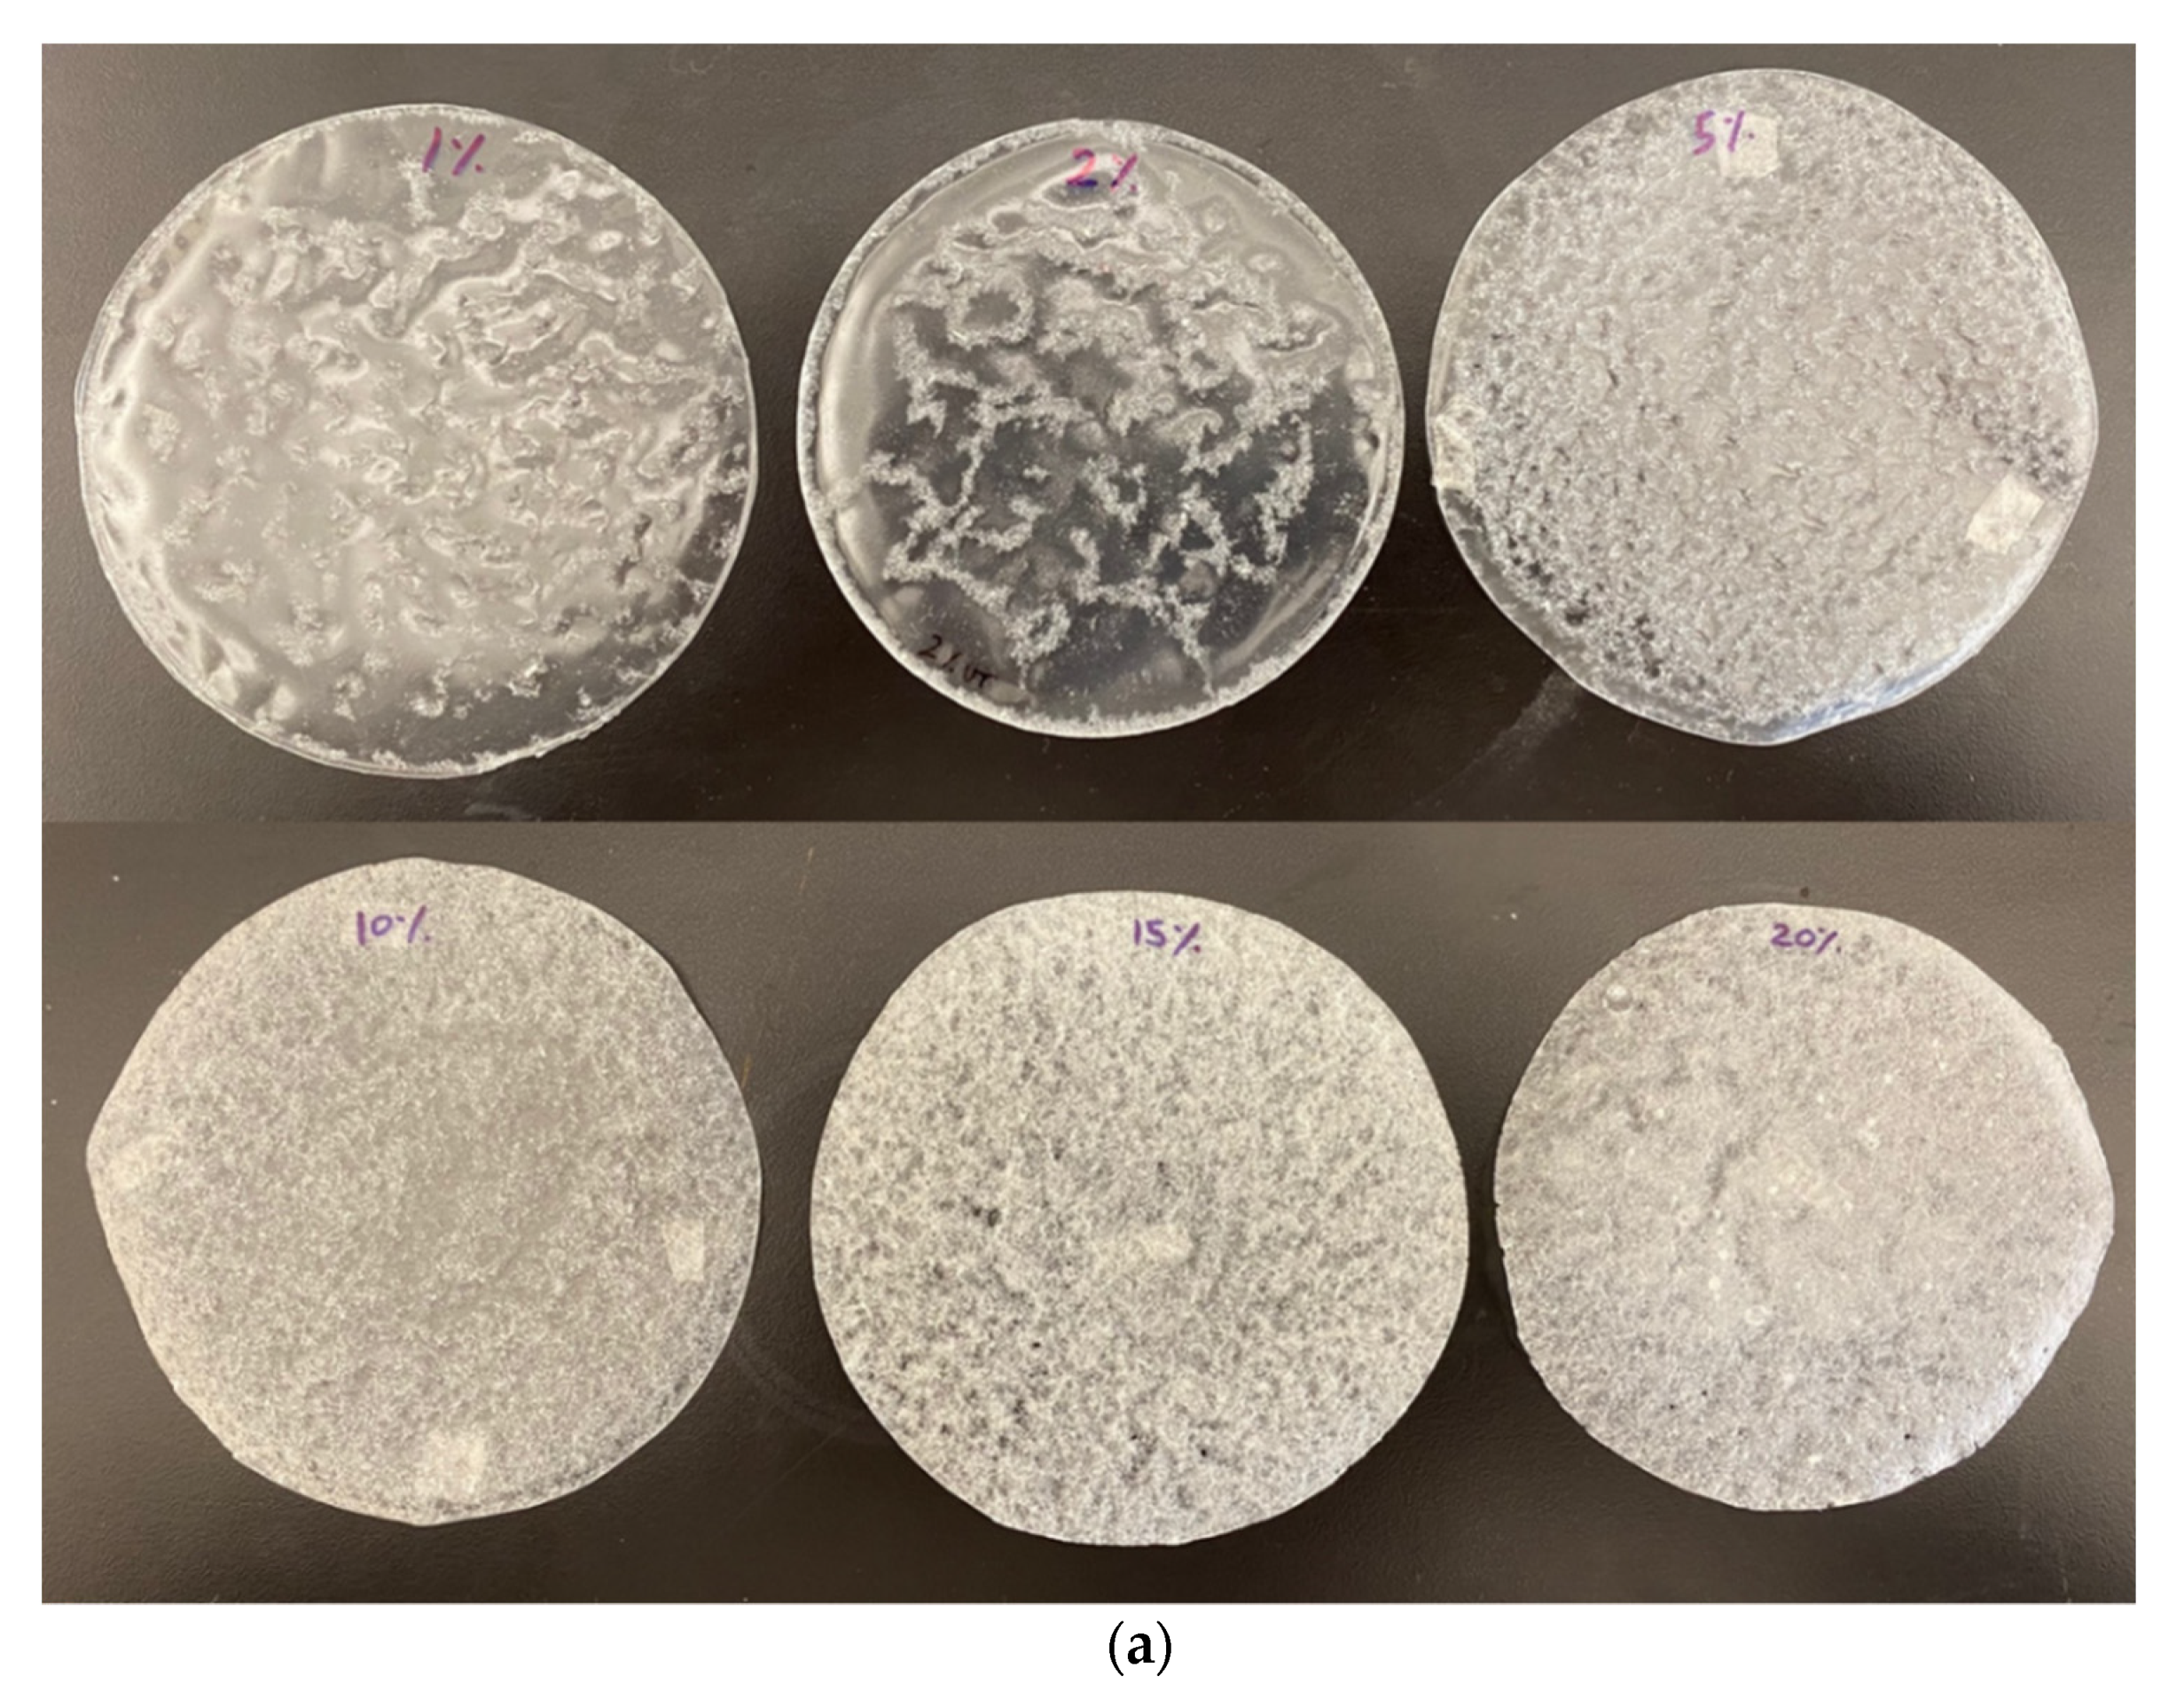
Materials 14 04310 g002a 550

Preparation of Breathable Cellulose Based Polymeric Membranes with Enhanced Water Resistance for the Building Industry
Abstract
:1. Introduction
2. Materials and Methods
2.1. Fiber Treatment
2.2. Film Preparation
2.3. Methods
2.3.1. Vapor Permeability and Water Vapor Transmission Rate (WVTR)
2.3.2. Water Retention
2.3.3. Scanning Electron Microscopy
2.3.4. Thermogravimetric Analysis
2.3.5. Differential Scanning Calorimetry
2.3.6. Dynamic Mechanical Analysis
3. Results and Discussion
4. Conclusions
Author Contributions
Funding
Informed Consent Statement
Data Availability Statement
Conflicts of Interest
References
- Viel, M.; Collet, F.; Lecieux, Y.; François, M.L.M.; Colson, V.; Lanos, C.; Hussain, A.; Lawrence, M. Resistance to mold development assessment of bio-based building materials. Compos. Part B Eng. 2019, 158, 406–418. [Google Scholar] [CrossRef]
- Wilkinson, J.; Ueno, K.; De Rose, D.; Straube, J.F.; Fugler, D. Understanding Vapour Permeance and Condensation in Wall Assemblies. In Proceedings of the 11th Canadian Building Science & Technology Conference, National Building Envelope Council 2007, Banff, AB, Canada, 3–5 November 2007; pp. 1–14. [Google Scholar]
- Agarwal, S.; Gupta, R.K. Plastics in Buildings and Construction. In Applied Plastics Engineering Handbook: Processing, Materials, and Applications, 2nd ed.; Elsevier: Amsterdam, The Netherlands, 2017; pp. 635–649. ISBN 9780323390408. [Google Scholar]
- Lstiburek, J.W. Understanding vapor barriers. ASHRAE J. 2004, 46, 40–47. [Google Scholar]
- Hussain, A.; Calabria-Holley, J.; Lawrence, M.; Jiang, Y. Hygrothermal and mechanical characterisation of novel hemp shiv based thermal insulation composites. Constr. Build. Mater. 2019, 212, 561–568. [Google Scholar] [CrossRef]
- Latif, E.; Tucker, S.; Ciupala, M.A.; Wijeyesekera, D.C.; Newport, D. Hygric properties of hemp bio-insulations with differing compositions. Constr. Build. Mater. 2014, 66, 702–711. [Google Scholar] [CrossRef] [Green Version]
- Stroeks, A. The moisture vapour transmission rate of block co-poly(ether- ester) based breathable films. 2. Influence of the thickness of the air layer adjacent to the film. Polymer 2001, 42, 09903–09908. [Google Scholar] [CrossRef]
- Straube, J.; Schumacher, C. Interior insulation retrofits of load-bearing masonry walls in cold climates. J. Green Build. 2007, 2, 42–50. [Google Scholar] [CrossRef]
- Straube, J.F. The influence of low-permeance vapor barriers on roof and wall performance. In Proceedings of the Thermal Performance of Whole Buildings VIII, Clearwater, FL, USA, 2–7 December 2001; pp. 1–12. [Google Scholar]
- Lafond, C.; Blanchet, P. Technical performance overview of bio-based expanded polystyrene. Buildings 2020, 10, 81. [Google Scholar] [CrossRef]
- Jiang, Y.; Lawrence, M.; Hussain, A.; Ansell, M.; Walker, P. Comparative moisture and heat sorption properties of fibre and shiv derived from hemp and flax. Cellulose 2019, 26, 823–843. [Google Scholar] [CrossRef] [Green Version]
- Ansell, M.P.; Lawrence, M.; Jiang, Y.; Shea, A.; Hussain, A.; Calabria-Holley, J.; Walker, P. Natural Plant-Based Aggregates and Bio-Composite Panels with Low Thermal Conductivity and High Hygrothermal Efficiency for Applications in Construction; Elsevier: Amsterdam, The Netherlands, 2019; ISBN 9780081027042. [Google Scholar]
- Segovia, F.; Blanchet, P.; Auclair, N.; Essoua Essoua, G.G. Thermo-Mechanical Properties of a Wood Fiber Insulation Board Using a Bio-Based Adhesive as a Binder. Buildings 2020, 10, 152. [Google Scholar] [CrossRef]
- Cabral, M.R.; Blanchet, P. A state of the art of the overall energy efficiency of wood buildings—An overview and future possibilities. Materials 2021, 14, 1848. [Google Scholar] [CrossRef]
- Maskell, D.; Thomson, A.; Walker, P.; Lemke, M. Determination of optimal plaster thickness for moisture buffering of indoor air. Build. Environ. 2018, 130, 143–150. [Google Scholar] [CrossRef]
- Tran Le, A.D.; Maalouf, C.; Mai, T.H.; Wurtz, E.; Collet, F. Transient hygrothermal behaviour of a hemp concrete building envelope. Energy Build. 2010, 42, 1797–1806. [Google Scholar] [CrossRef]
- Lawrence, M. Reducing the Environmental Impact of Construction by Using Renewable Materials. J. Renew. Mater. 2015, 3, 163–174. [Google Scholar] [CrossRef] [Green Version]
- MELCC. Politique-Cadre D’Électrification et de Lutte Contre Les Changements Climatiques; Gouvernement du Québec: Québec, QC, Canada, 2020; ISBN 9782550862796.
- Lessard, Y.; Anand, C.; Blanchet, P.; Frenette, C.; Amor, B. LEED v4: Where Are We Now? Critical Assessment through the LCA of an Office Building Using a Low Impact Energy Consumption Mix. J. Ind. Ecol. 2018, 22, 1105–1116. [Google Scholar] [CrossRef]
- Phanthong, P.; Reubroycharoen, P.; Hao, X.; Xu, G.; Abudula, A.; Guan, G. Nanocellulose: Extraction and application. Carbon Resour. Convers. 2018, 1, 32–43. [Google Scholar] [CrossRef]
- Abdul Khalil, H.P.S.; Bhat, A.H.; Ireana Yusra, A.F. Green composites from sustainable cellulose nanofibrils: A review. Carbohydr. Polym. 2012, 87, 963–979. [Google Scholar] [CrossRef]
- Jonoobi, M.; Harun, J.; Mathew, A.P.; Oksman, K. Mechanical properties of cellulose nanofiber (CNF) reinforced polylactic acid (PLA) prepared by twin screw extrusion. Compos. Sci. Technol. 2010, 70, 1742–1747. [Google Scholar] [CrossRef]
- Sharma, A.; Thakur, M.; Bhattacharya, M.; Mandal, T.; Goswami, S. Commercial application of cellulose nano-composites—A review. Biotechnol. Rep. 2019, 21, e00316. [Google Scholar] [CrossRef]
- Erbas Kiziltas, E.; Kiziltas, A.; Bollin, S.C.; Gardner, D.J. Preparation and characterization of transparent PMMA-cellulose-based nanocomposites. Carbohydr. Polym. 2015, 127, 381–389. [Google Scholar] [CrossRef]
- Spence, K.L.; Venditti, R.A.; Rojas, O.J.; Pawlak, J.J.; Hubbe, M.A. Water Vapor Barrier Properties of Microfibrillated Cellulose Films. BioResources 2011, 6, 4370–4388. [Google Scholar] [CrossRef]
- Song, Z.; Xiao, H.; Zhao, Y. Hydrophobic-modified nano-cellulose fiber/PLA biodegradable composites for lowering water vapor transmission rate (WVTR) of paper. Carbohydr. Polym. 2014, 111, 442–448. [Google Scholar] [CrossRef] [PubMed]
- Fortunati, E.; Peltzer, M.; Armentano, I.; Torre, L.; Jiménez, A.; Kenny, J.M. Effects of modified cellulose nanocrystals on the barrier and migration properties of PLA nano-biocomposites. Carbohydr. Polym. 2012, 90, 948–956. [Google Scholar] [CrossRef]
- Hospodarova, V.; Stevulova, N. Investigation of Waste Paper Cellulosic Fibers Utilization into Cement Based Building Materials. Buildings 2018, 8, 43. [Google Scholar] [CrossRef] [Green Version]
- Yi, T.; Zhao, H.; Mo, Q.; Pan, D.; Liu, Y.; Huang, L.; Xu, H. From Cellulose to Cellulose Nanofibrils—A Comprehensive Review of the Preparation and Modification of Cellulose Nanofibrils. Materials 2020, 13, 5062. [Google Scholar] [CrossRef] [PubMed]
- Lawrence, M.; Fodde, E.; Paine, K.; Walker, P. Hygrothermal Performance of an Experimental Hemp-Lime Building. Key Eng. Mater. 2012, 517, 413–421. [Google Scholar] [CrossRef] [Green Version]
- Stevulova, N.; Cigasova, J.; Schwarzova, I.; Sicakova, A.; Junak, J. Sustainable bio-aggregate-based composites containing hemp hurds and alternative binder. Buildings 2018, 8, 25. [Google Scholar] [CrossRef] [Green Version]
- Cichosz, S.; Masek, A.; Rylski, A. Cellulose Modification for Improved Compatibility with the Polymer Matrix: Mechanical Characterization of the Composite Material. Materials 2020, 13, 5519. [Google Scholar] [CrossRef]
- Kabir, M.M.; Wang, H.; Lau, K.T.; Cardona, F. Chemical treatments on plant-based natural fibre reinforced polymer composites: An overview. Compos. Part B Eng. 2012, 43, 2883–2892. [Google Scholar] [CrossRef]
- Bledzki, A.K.; Mamun, A.A.; Lucka-Gabor, M.; Gutowski, V.S. The effects of acetylation on properties of flax fibre and its polypropylene composites. Express Polym. Lett. 2008, 2, 413–422. [Google Scholar] [CrossRef]
- Phan-Xuan, T.; Thuresson, A.; Skepö, M.; Labrador, A.; Bordes, R.; Matic, A. Aggregation behavior of aqueous cellulose nanocrystals: The effect of inorganic salts. Cellulose 2016, 23, 3653–3663. [Google Scholar] [CrossRef] [Green Version]
- Yasin, S.; Hussain, M.; Zheng, Q.; Song, Y. Large amplitude oscillatory rheology of silica and cellulose nanocrystals filled natural rubber compounds. J. Colloid Interface Sci. 2021, 588, 602–610. [Google Scholar] [CrossRef]
- Yasin, S.; Hussain, M.; Zheng, Q.; Song, Y. Effects of ionic liquid on cellulosic nanofiller filled natural rubber bionanocomposites. J. Colloid Interface Sci. 2021, 591, 409–417. [Google Scholar] [CrossRef] [PubMed]
- Cerny, P.; Bartos, P.; Kriz, P.; Olsan, P.; Spatenka, P. Highly Hydrophobic Organosilane-Functionalized Cellulose: A Promising Filler for Thermoplastic Composites. Materials 2021, 14, 2005. [Google Scholar] [CrossRef] [PubMed]
- Hussain, A.; Calabria-Holley, J.; Lawrence, M.; Ansell, M.P.; Jiang, Y.; Schorr, D.; Blanchet, P. Development of novel building composites based on hemp and multi-functional silica matrix. Compos. Part B Eng. 2019, 156, 266–273. [Google Scholar] [CrossRef]
- Fortunati, E.; Rinaldi, S.; Peltzer, M.; Bloise, N.; Visai, L.; Armentano, I.; Jiménez, A.; Latterini, L.; Kenny, J.M. Nano-biocomposite films with modified cellulose nanocrystals and synthesized silver nanoparticles. Carbohydr. Polym. 2014, 101, 1122–1133. [Google Scholar] [CrossRef] [PubMed] [Green Version]
- Kaboorani, A.; Riedl, B. Surface modification of cellulose nanocrystals (CNC) by a cationic surfactant. Ind. Crops Prod. 2015, 65, 45–55. [Google Scholar] [CrossRef]
- Collet, F.; Chamoin, J.; Pretot, S.; Lanos, C. Comparison of the hygric behaviour of three hemp concretes. Energy Build. 2013, 62, 294–303. [Google Scholar] [CrossRef]
- Derome, D.; Derluyn, H.; Zillig, W.A.; Carmeliet, J. Model for hysteretic moisture behaviour of wood. In Proceedings of the Nordic Symposium on Building Physics 2008, Copenhagen, Denmark, 16–18 June 2008; Volume 2, pp. 959–966. [Google Scholar]
- Shamsuri, A.A.; Md Jamil, S.N.A. A short review on the effect of surfactants on the mechanico-thermal properties of polymer nanocomposites. Appl. Sci. 2020, 10, 4867. [Google Scholar] [CrossRef]
- Fortunati, E.; Armentano, I.; Zhou, Q.; Iannoni, A.; Saino, E.; Visai, L.; Berglund, L.A.; Kenny, J.M. Multifunctional bionanocomposite films of poly(lactic acid), cellulose nanocrystals and silver nanoparticles. Carbohydr. Polym. 2012, 87, 1596–1605. [Google Scholar] [CrossRef]
- Bondeson, D.; Oksman, K. Dispersion and characteristics of surfactant modified cellulose whiskers nanocomposites. Compos. Interfaces 2007, 14, 617–630. [Google Scholar] [CrossRef]
- Heux, L.; Chauve, G.; Bonini, C. Nonflocculating and chiral-nematic self-ordering of cellulose microcrystals suspensions in nonpolar solvents. Langmuir 2000, 16, 8210–8212. [Google Scholar] [CrossRef]
- Moreno, M.; Armentano, I.; Fortunati, E.; Mattioli, S.; Torre, L.; Lligadas, G.; Ronda, J.C.; Galià, M.; Cádiz, V. Cellulose nano-biocomposites from high oleic sunflower oil-derived thermosets. Eur. Polym. J. 2016, 79, 109–120. [Google Scholar] [CrossRef]
- Ljungberg, N.; Cavaillé, J.Y.; Heux, L. Nanocomposites of isotactic polypropylene reinforced with rod-like cellulose whiskers. Polymer 2006, 47, 6285–6292. [Google Scholar] [CrossRef]

| Sample | PLA Conc. (wt%) | CF Conc. (wt%) | Surfactant Treated |
|---|---|---|---|
| PLA | 100 | 0 | - |
| UCF | 0 | 100 | - |
| TCF | 0 | 100 | Yes |
| PLA-UCF1 | 99 | 1 | - |
| PLA-UCF2 | 98 | 2 | - |
| PLA-UCF5 | 95 | 5 | - |
| PLA-UCF10 | 90 | 10 | - |
| PLA-UCF15 | 85 | 15 | - |
| PLA-UCF20 | 80 | 20 | - |
| PLA-TCF1 | 99 | 1 | Yes |
| PLA-TCF2 | 98 | 2 | Yes |
| PLA-TCF5 | 95 | 5 | Yes |
| PLA-TCF10 | 90 | 10 | Yes |
| PLA-TCF15 | 85 | 15 | Yes |
| PLA-TCF20 | 80 | 20 | Yes |
| Sample | WVTR (g/(h∙m²)) | Thickness (mm) | Permeability P (g/(h∙m∙Pa)) × 10−7 | Normalized WVTR (g∙m/(h∙m²)) × 10−5 | Normalized WVTR (g∙mils/(day∙m²)) |
|---|---|---|---|---|---|
| PLA | −2.21 ± 0.03 | 0.11 ± 0.01 | −2.01 ± 0.12 | −24.33 ± 1.47 | −229.90 ± 13.96 |
| PLA-UCF1 | −1.26 ± 0.04 | 0.19 ± 0.01 | −1.99 ± 0.03 | −24.09 ± 0.34 | −227.65 ± 3.26 |
| PLA-UCF2 | −1.32 ± 0.04 | 0.20 ± 0.01 | −2.19 ± 0.02 | −26.54 ± 0.25 | −250.83 ± 2.38 |
| PLA-UCF5 | −1.70 ± 0.06 | 0.26 ± 0.02 | −3.66 ± 0.13 | −44.31 ± 1.59 | −418.68 ± 15.05 |
| PLA-UCF10 | −1.98 ± 0.03 | 0.30 ± 0.01 | −4.92 ± 0.14 | −59.60 ± 1.74 | −563.19 ± 16.49 |
| PLA-UCF15 | −3.16 ± 0.24 | 0.32 ± 0.02 | −8.36 ± 0.54 | −101.15 ± 6.71 | −955.79 ± 60.04 |
| PLA-UCF20 | −10.28 ± 0.16 | 0.42 ± 0.02 | −35.71 ± 1.58 | −432.14 ± 19.12 | −4083.21 ± 181.20 |
| PLA-TCF1 | −1.28 ± 0.03 | 0.19 ± 0.01 | −2.01 ± 0.12 | −24.40 ± 1.46 | −230.60 ± 13.80 |
| PLA-TCF2 | −1.42 ± 0.04 | 0.19 ± 0.01 | −2.24 ± 0.11 | −27.16 ± 1.34 | −256.61 ± 12.71 |
| PLA-TCF5 | −1.79 ± 0.06 | 0.25 ± 0.01 | −3.71 ± 0.20 | −44.87 ± 2.45 | −423.97 ± 23.21 |
| PLA-TCF10 | −2.97 ± 0.13 | 0.20 ± 0.01 | −4.91 ± 0.39 | −59.46 ± 4.80 | −561.85 ± 45.38 |
| PLA-TCF15 | −2.61 ± 0.10 | 0.26 ± 0.02 | −5.61 ± 0.49 | −67.92 ± 5.97 | −641.81 ± 56.41 |
| PLA-TCF20 | −4.79 ± 0.15 | 0.25 ± 0.01 | −9.92 ± 0.61 | −119.97 ± 7.40 | −1133.58 ± 69.90 |
| Sample | Melting Point (°C) | Melting Enthalpy (mJ) | Tg (°C) | Tmax (°C) | Residue (%) |
|---|---|---|---|---|---|
| PLA | 153.6 ± 0.9 | −128.6 ± 0.3 | 61.5 ± 0.5 | 368.1 ± 0.2 | 0.5 ± 0.01 |
| PLA-UCF20 | 153.5 ± 0.6 | −90.6 ± 0.2 | 61.3 ± 0.3 | 354.9 ± 0.1 | 2.4 ± 0.04 |
| PLA-TCF20 | 153.7 ± 0.5 | −120.2 ± 0.3 | 65.5 ± 0.5 | 372.5 ± 0.1 | 3.6 ± 0.03 |
| UCF | - | - | - | 361.2 ± 0.3 | 8.4 ± 0.04 |
| TCF | - | - | - | 269.3 ± 0.2 | 23.8 ± 0.12 |
Publisher’s Note: MDPI stays neutral with regard to jurisdictional claims in published maps and institutional affiliations. |
© 2021 by the authors. Licensee MDPI, Basel, Switzerland. This article is an open access article distributed under the terms and conditions of the Creative Commons Attribution (CC BY) license (https://creativecommons.org/licenses/by/4.0/).
Share and Cite
Hussain, A.; Blanchet, P. Preparation of Breathable Cellulose Based Polymeric Membranes with Enhanced Water Resistance for the Building Industry. Materials 2021, 14, 4310. https://doi.org/10.3390/ma14154310
Hussain A, Blanchet P. Preparation of Breathable Cellulose Based Polymeric Membranes with Enhanced Water Resistance for the Building Industry. Materials. 2021; 14(15):4310. https://doi.org/10.3390/ma14154310
Chicago/Turabian StyleHussain, Atif, and Pierre Blanchet. 2021. "Preparation of Breathable Cellulose Based Polymeric Membranes with Enhanced Water Resistance for the Building Industry" Materials 14, no. 15: 4310. https://doi.org/10.3390/ma14154310
APA StyleHussain, A., & Blanchet, P. (2021). Preparation of Breathable Cellulose Based Polymeric Membranes with Enhanced Water Resistance for the Building Industry. Materials, 14(15), 4310. https://doi.org/10.3390/ma14154310







